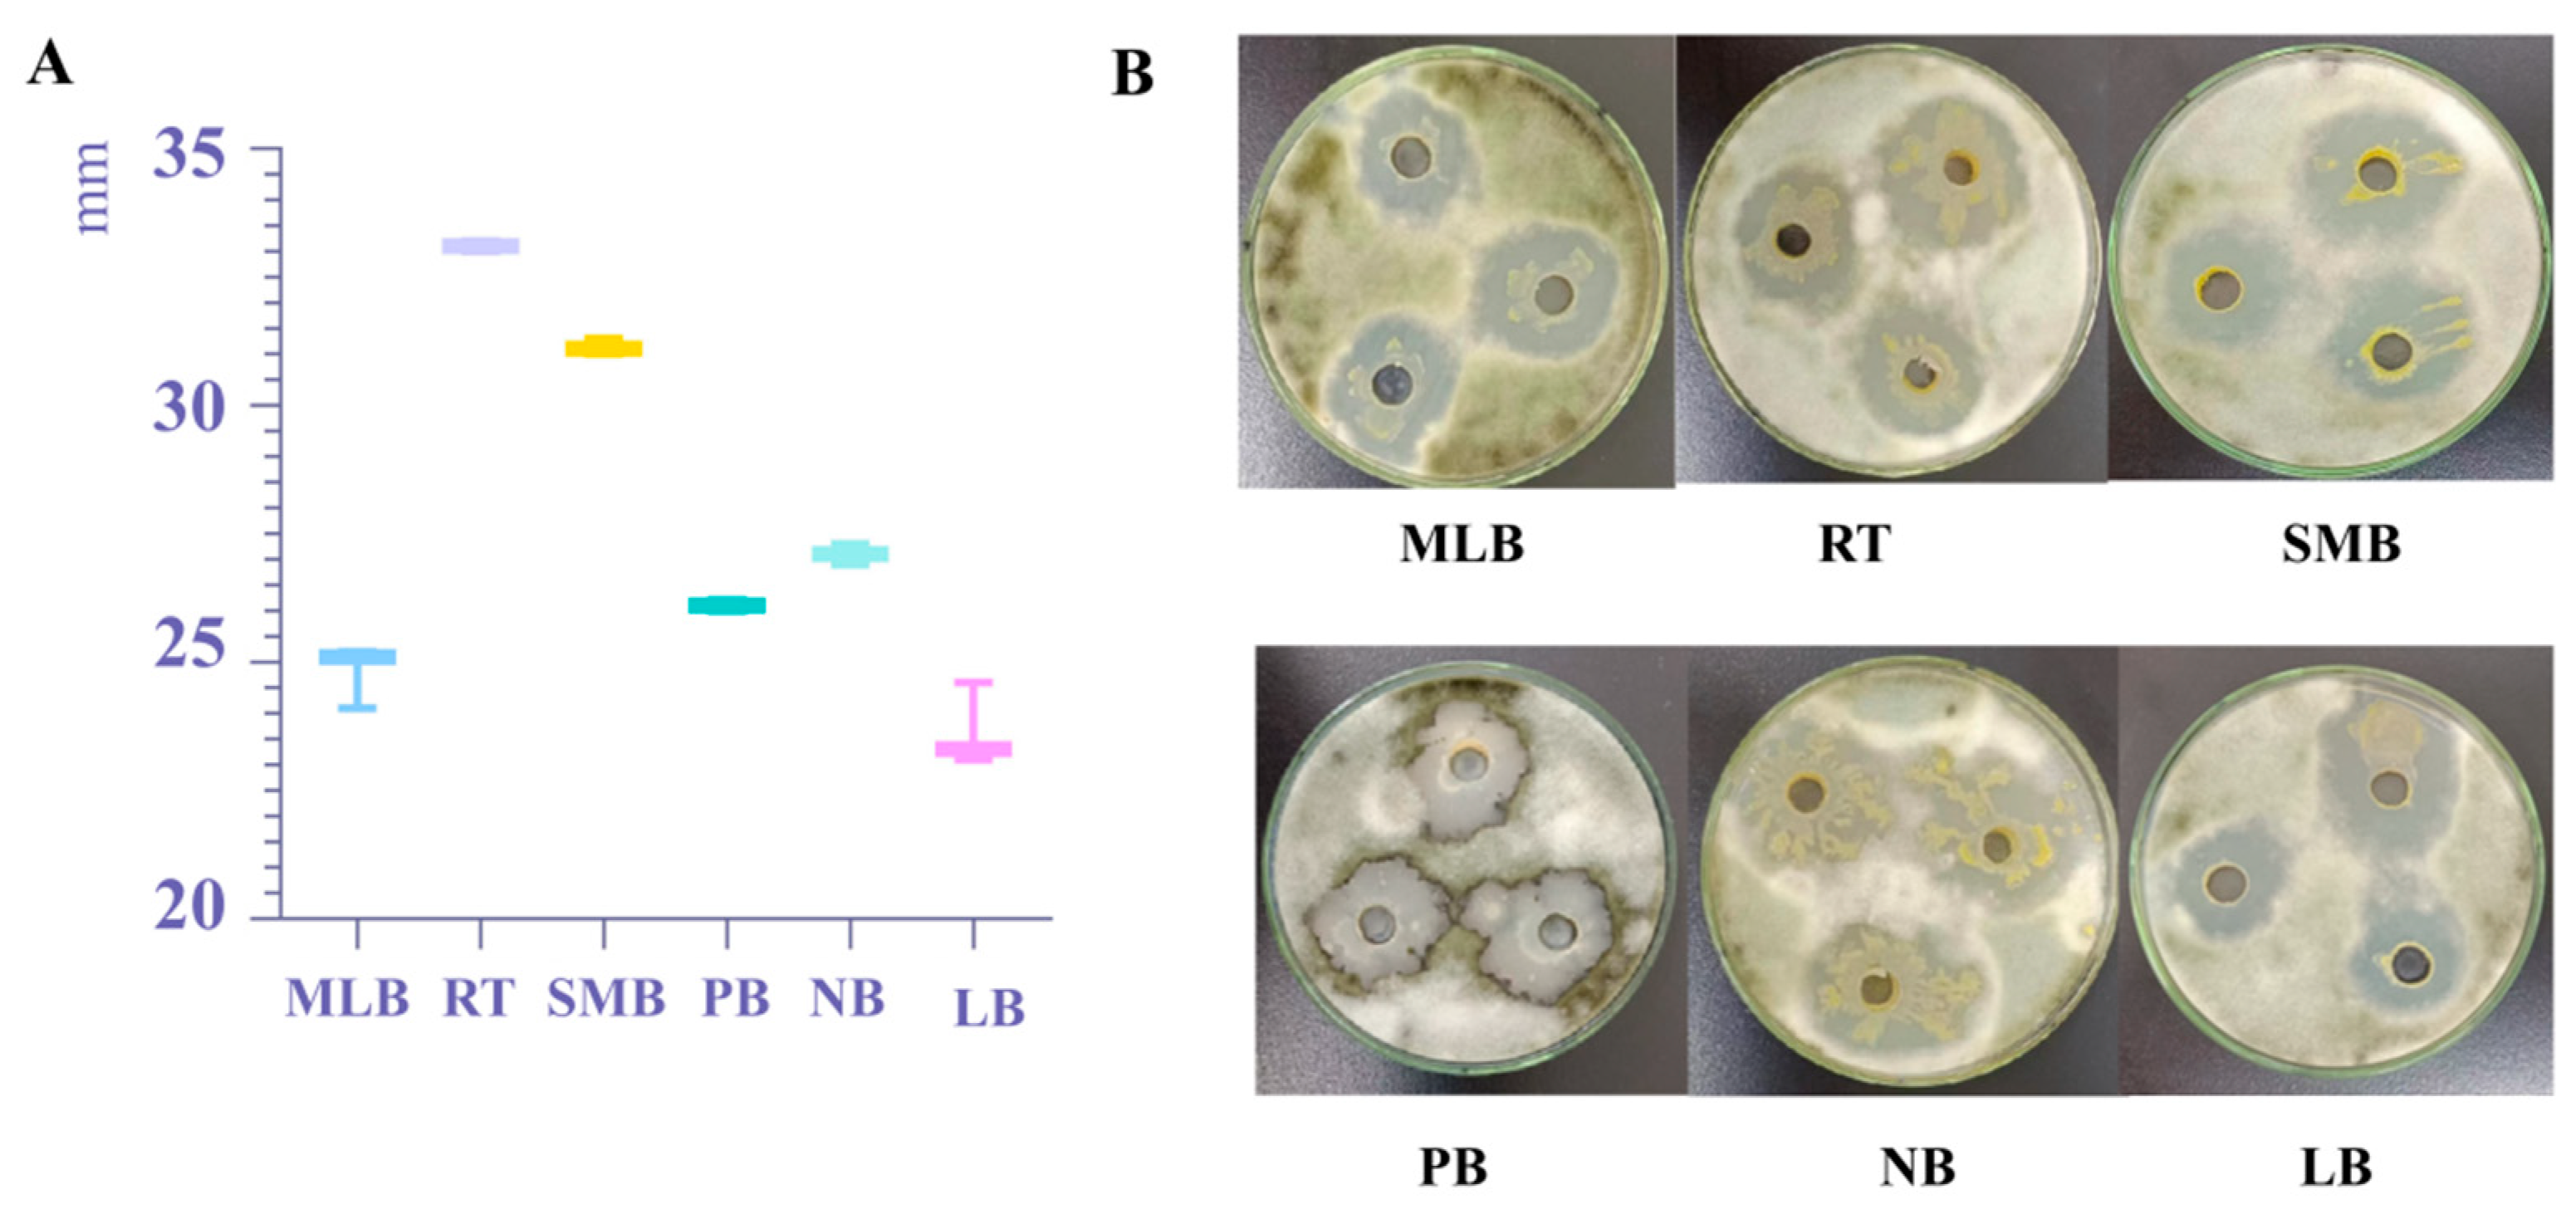
Biology 14 00793 g005
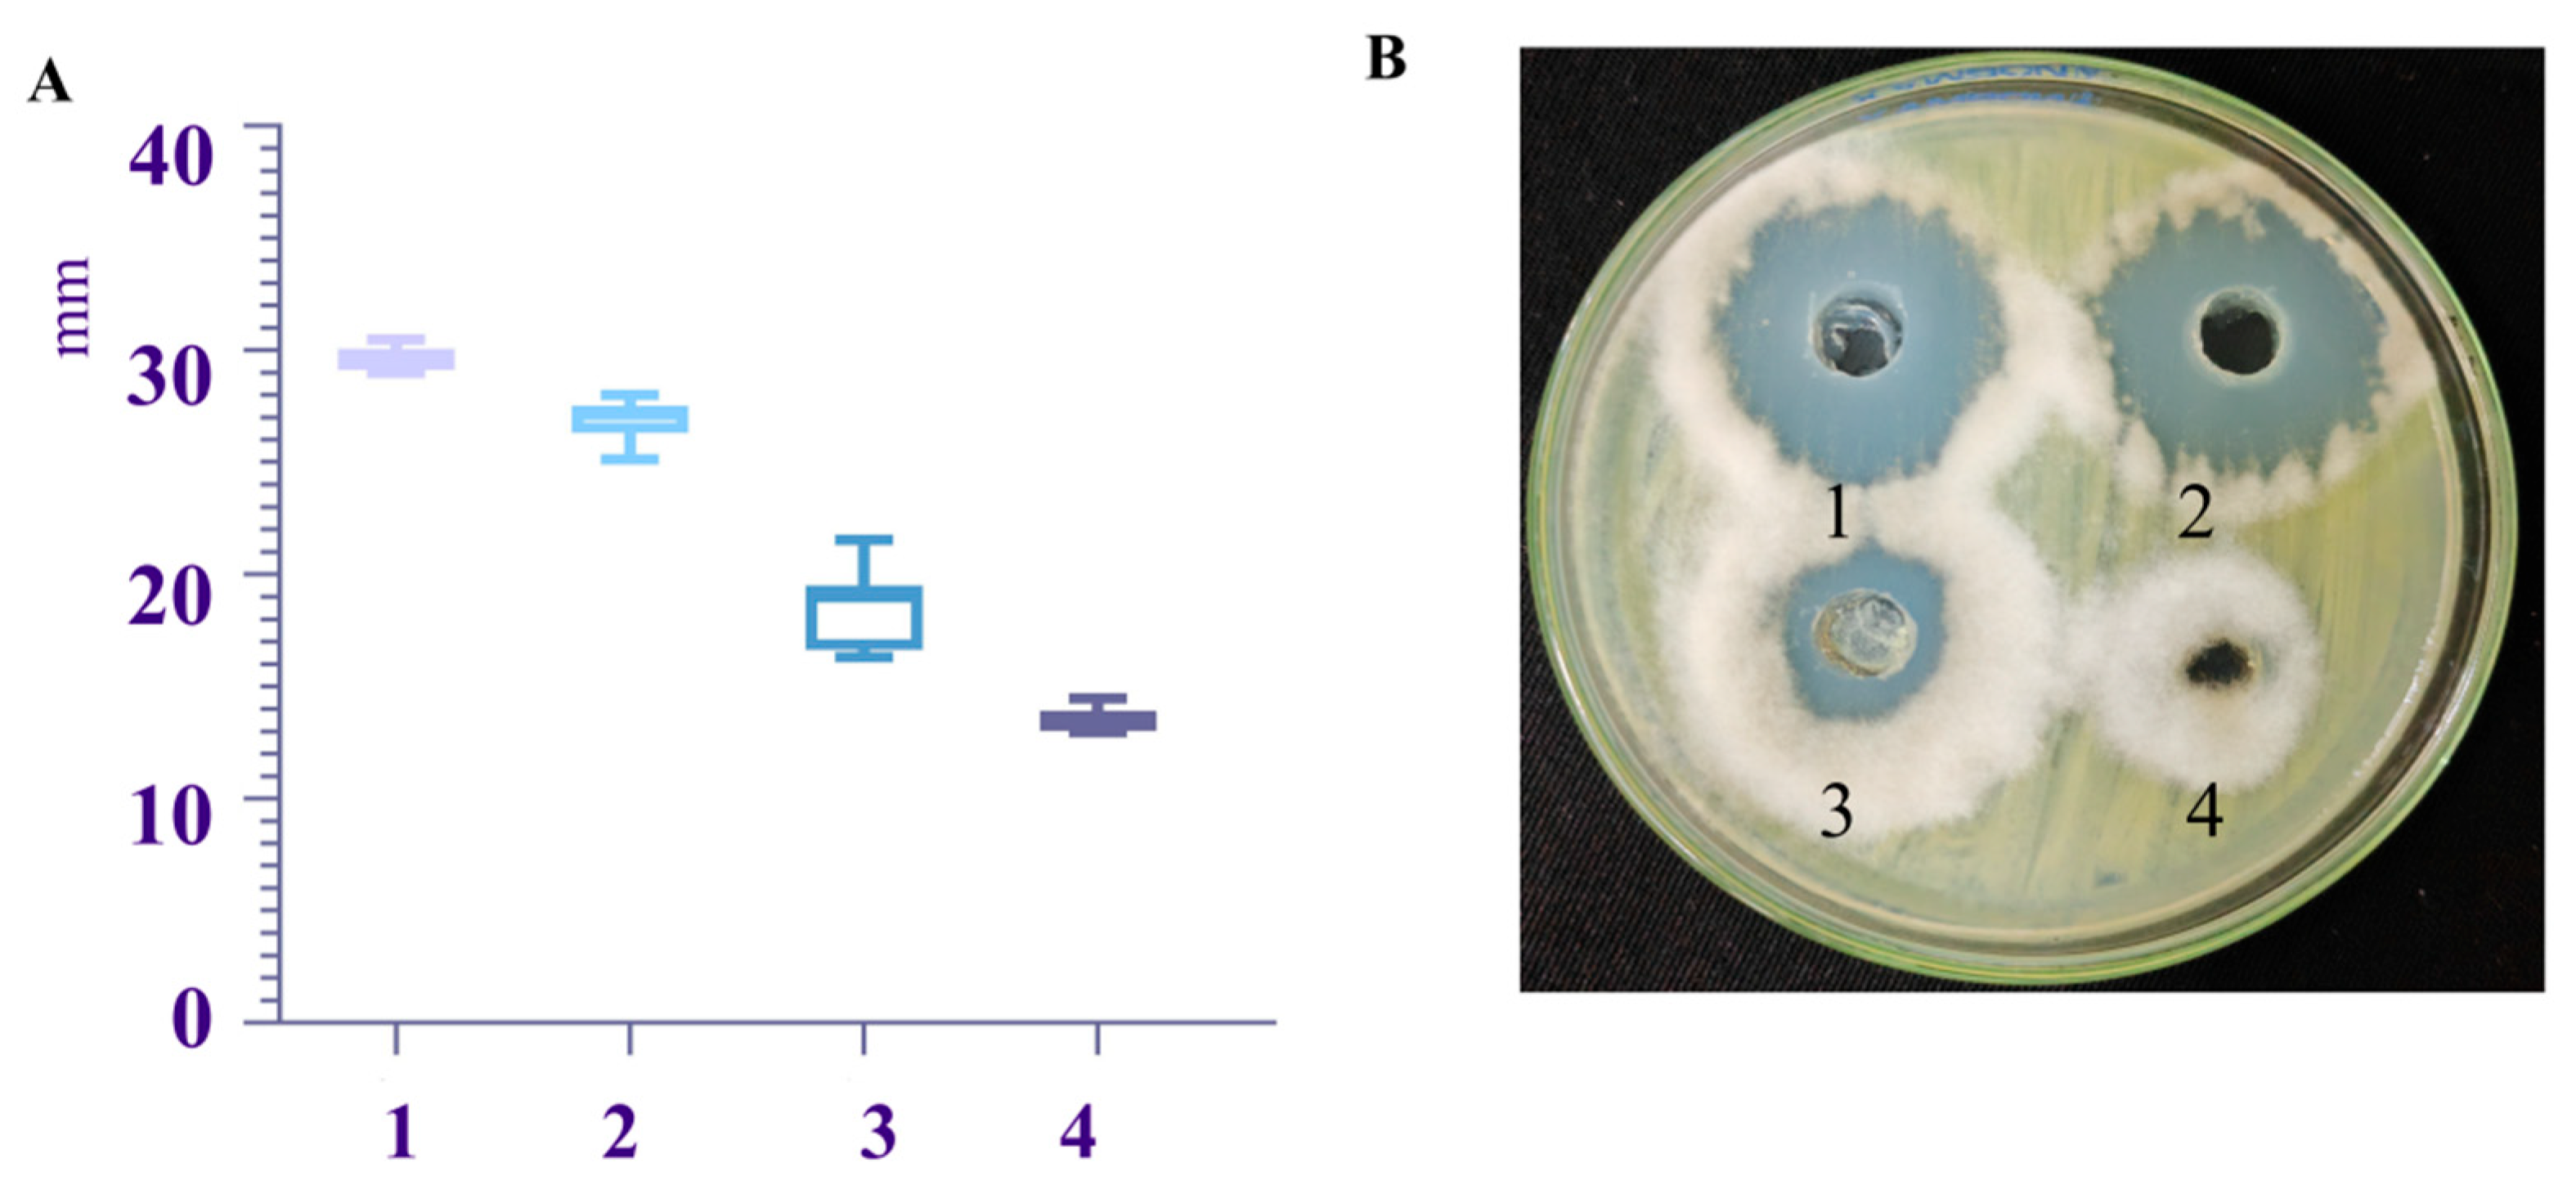
Biology 14 00793 g006
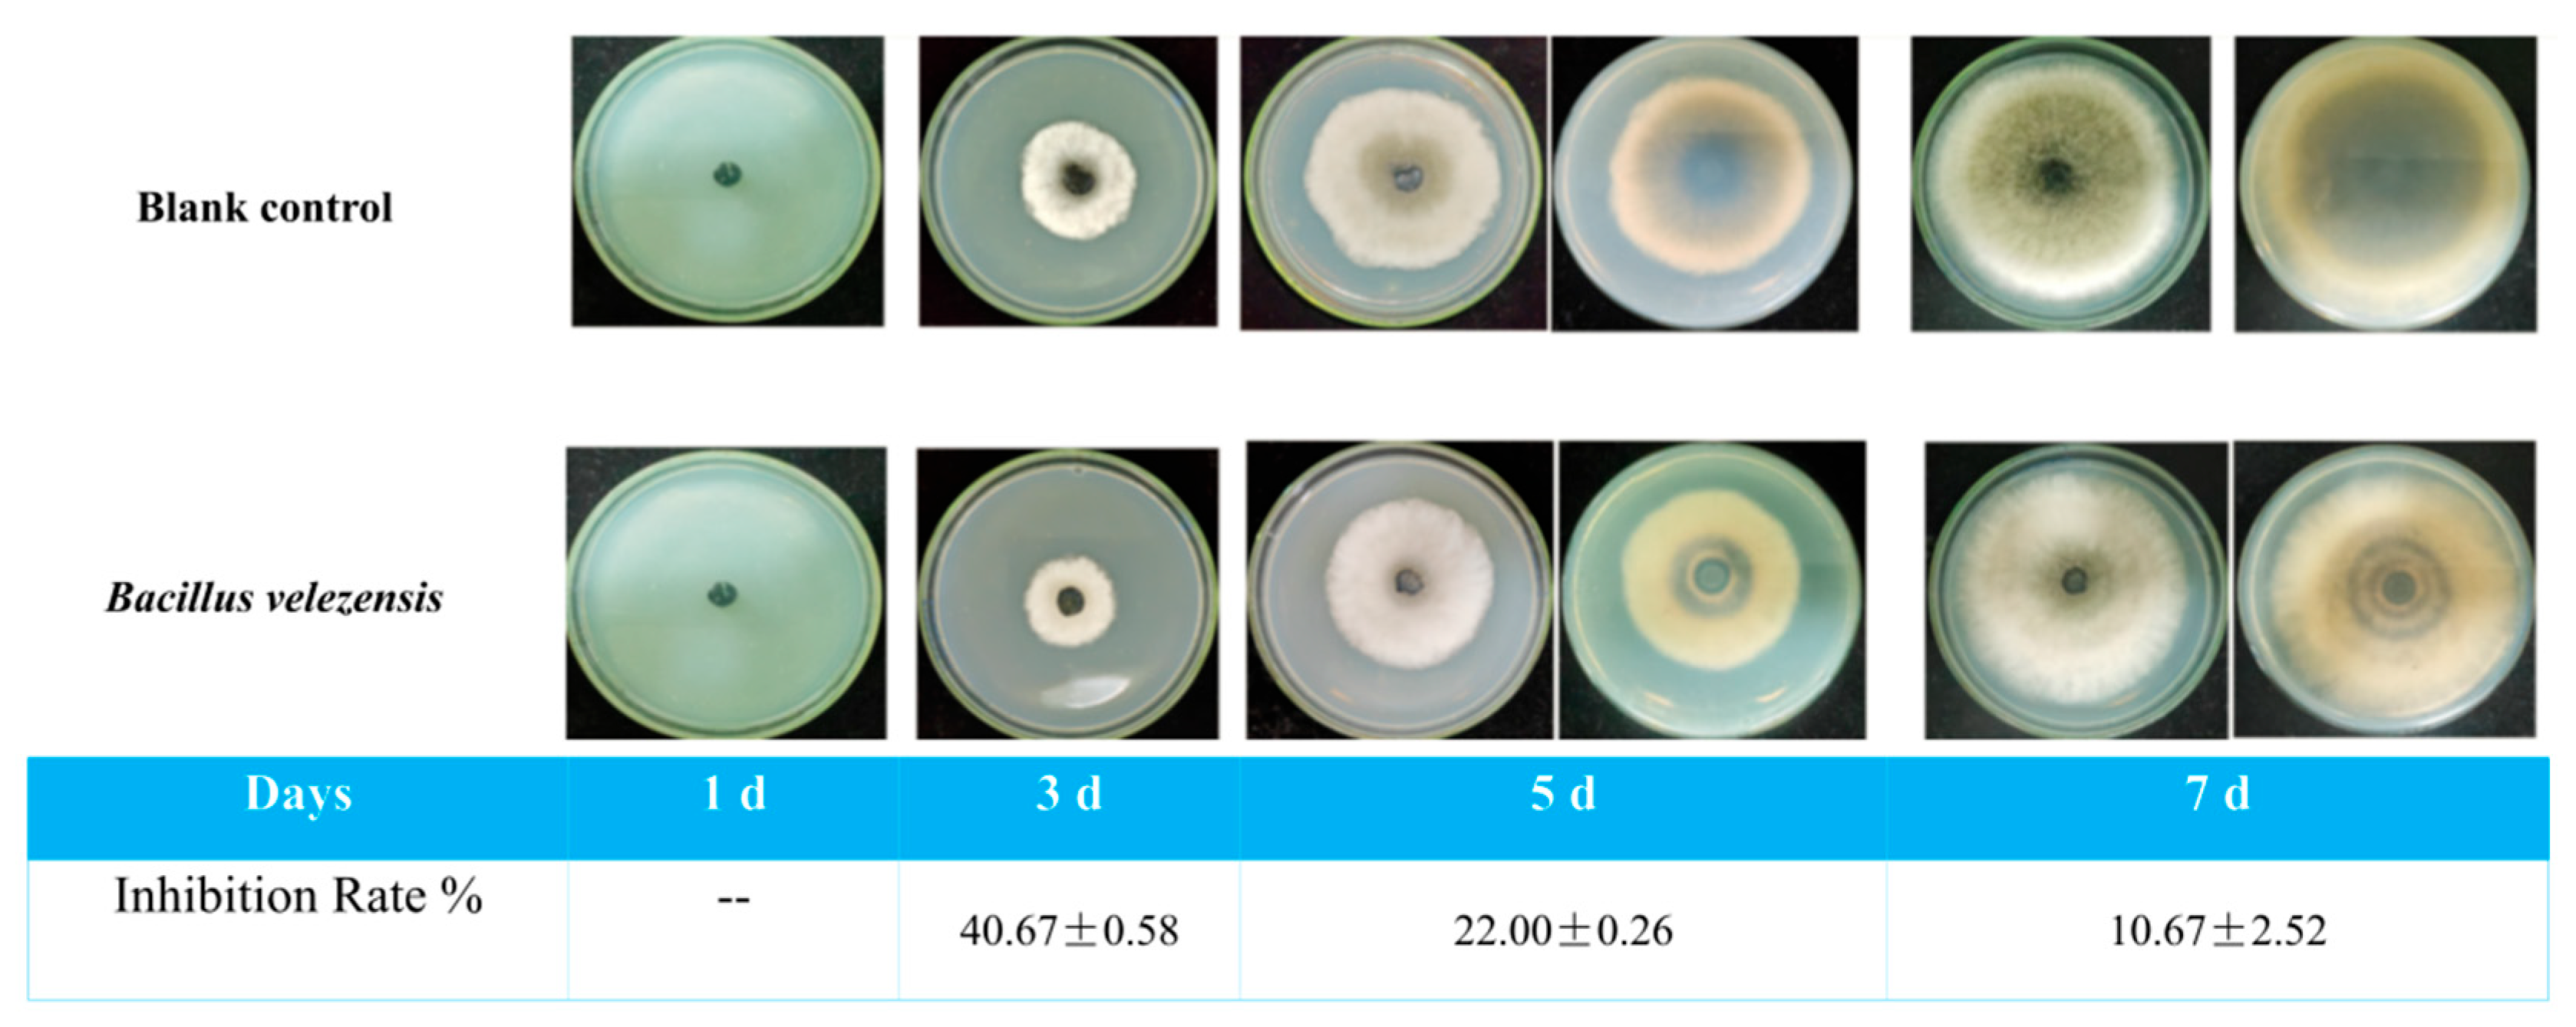
Biology 14 00793 g007
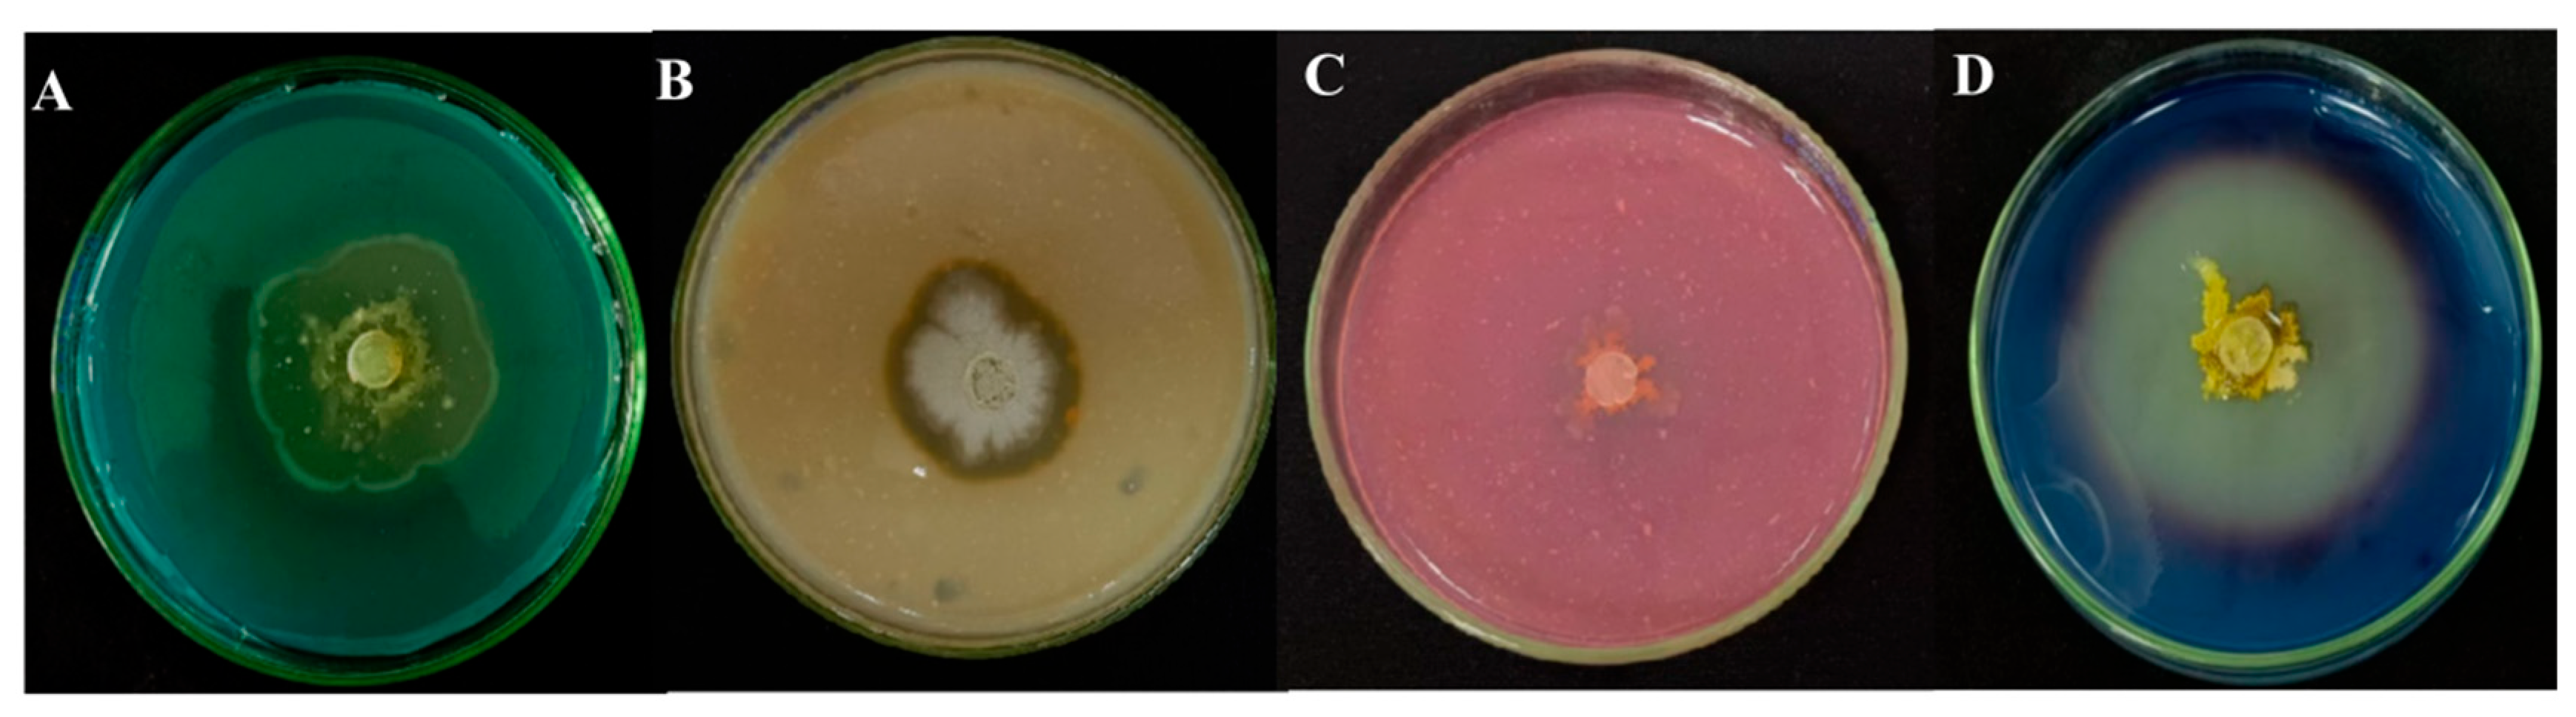
Biology 14 00793 g008

Biocontrol Effect and Antibacterial Mechanism of Bacillus velezensis TRMB57782 Against Alternaria gaisen Blotch in Korla Pears
Simple Summary
Abstract
1. Introduction
2. Materials and Methods
2.1. Microbiological Material
2.2. Strain TRMB57782 Genetic Classification Status Determination
2.2.1. Methods for Identification of Strain TRMB57782
2.2.2. Methods for Comparative Genomic Analysis of Strain TRMB57782
2.2.3. Analysis of Antibacterial Potential of Strain TRMB57782 Based on Genomics
2.3. Strain TRMB57782 Biological Activity Determination
2.3.1. Antimicrobial Effect Test of Fermentation Broths from Different Media on Pathogenic Fungi A. gaisen
2.3.2. Evaluation of the Biocontrol Effect of Strain TRMB57782
- (1)
- Determination of the Preventive and Therapeutic Effects on Detached Branches
- (2)
- Determination of the Preventive and Therapeutic Effects on Detached Young Fruits
- (3)
- Determination of the Preventive and Therapeutic Effects on Ripe Fruits
2.4. Mechanisms of Strain TRMB57782 Against Pear Black Spot Pathogen
2.4.1. Determination of Antibacterial Activity of Antagonistic Substance Crude Extract of Strain TRMB57782
2.4.2. Spatiotemporal Inhibitory Effects of VOCs on the Mycelial Expansion of Pear Black Spot Pathogen
2.4.3. Qualitative Detection of Extracellular Enzyme and Siderophore Activity
2.4.4. Effect of Strain TRMB57782 on the Morphology of Pear Black—Spot Pathogen Hyphae
2.5. Data Processing and Analysis
3. Results
3.1. Determination of the Genetic Taxonomic Status of Strain TRMB57782
3.1.1. Analysis of the Identification of Strain TRMB57782
3.1.2. Comparative Genomic Analysis of Strain TRMB57782
3.1.3. Elucidating the Antibacterial Potential of Strain TRMB57782 Through Genomic Analysis
3.2. Strain TRMB57782 Activity Determination
3.2.1. Antibacterial Effect Test of Different Culture Media Fermentation Broth on Pathogenic Fungi A. gaisen
3.2.2. Biocontrol Effect Determination
- (1)
- Investigation into the preventive and curative impacts on detached branches
- (2)
- Investigation of Preventive and Curative Effects on Young Fruits throughout the Growth Phase
- (3)
- Investigation of the Preventive and Curative Effects on Fruits throughout the Storage Duration
3.3. Mechanisms of Strain TRMB57782 Antagonizing Black Spot Disease in Pears
Determination of Antibacterial Activity of Antagonistic Substance Crude Extract by Strain TRMB57782
3.4. Spatiotemporal Inhibitory Effects of VOCs on the Mycelial Expansion of Pear Black Spot Pathogen
3.5. Qualitative Detection of Extracellular Enzyme and Siderophore Activity
3.6. Effect of Strain TRMB57782 on the Morphology of Pear Black Spot Pathogen Hyphae
4. Discussion
5. Conclusions
Supplementary Materials
Author Contributions
Funding
Institutional Review Board Statement
Informed Consent Statement
Data Availability Statement
Conflicts of Interest
References
- Cheng, S.; Ouyang, H.; Guo, W.; Guo, M.; Chen, G.; Tian, H. Proteomic and physiological analysis of ‘Korla’ fragrant pears (Pyrus × brestschneideri Rehd) during postharvest under cold storage. Sci. Hortic. 2021, 288, 110428. [Google Scholar] [CrossRef]
- Jiang, W.; Yan, P.; Zheng, Q.; Wang, Z.; Chen, Q.; Wang, Y. Changes in the Metabolome and Nutritional Quality of Pulp from Three Types of Korla Fragrant Pears with Different Appearances as Revealed by Widely Targeted Metabolomics. Plants 2023, 12, 3981. [Google Scholar] [CrossRef] [PubMed]
- Oyom, W.; Li, Y.; Prusky, D.; Zhang, Z.; Bi, Y.; Tahergorabi, R. Recent advances in postharvest technology of Asia pears fungi disease control: A review. Physiol. Mol. Plant Pathol. 2022, 117, 101771. [Google Scholar] [CrossRef]
- Sun, T.; Ouyang, H.; Sun, P.; Zhang, W.; Wang, Y.; Cheng, S.; Chen, G. Postharvest UV-C irradiation inhibits blackhead disease by inducing disease resistance and reducing mycotoxin production in ‘Korla’ fragrant pear (Pyrus sinkiangensis). Int. J. Food Microbiol. 2022, 362, 109485. [Google Scholar] [CrossRef] [PubMed]
- Sun, T.; Yang, W.; Sun, P.; Liu, X.; Ma, W.; Cheng, S.; Chen, G. Alternaria alternata stimulates blackhead disease development of ‘Korla’ fragrant pear (Pyrus bretschneideri Rehd) by regulating energy status and respiratory metabolism. Postharvest Biol. Technol. 2023, 202, 112386. [Google Scholar] [CrossRef]
- Aichinger, G.; Del Favero, G.; Warth, B.; Marko, D. Alternaria toxins-Still emerging? Compr. Rev. Food Sci. Food Saf. 2021, 20, 4390–4406. [Google Scholar] [CrossRef]
- Chen, A.; Mao, X.; Sun, Q.; Wei, Z.X.; Li, J.; You, Y.L.; Zhao, J.Q.; Jiang, G.B.; Ning, Y.; Wang, W.L. Alternaria Mycotoxins: An Overview of Toxicity, Metabolism, and Analysis in Food. J. Agric. Food Chem. 2021, 69, 7817–7830. [Google Scholar] [CrossRef]
- Sardella, D.; Muscat, A.; Brincat, J.P.; Gatt, R.; Decelis, S.; Valdramidis, V. A Comprehensive Review of the Pear Fungal Diseases. Int. J. Fruit Sci. 2016, 16, 351–377. [Google Scholar] [CrossRef]
- Boudh, S.; Singh, J.S. Pesticide Contamination: Environmental Problems and Remediation Strategies; Bharagava, R., Chowdhary, P., Eds.; Emerging and Eco-Friendly Approaches for Waste Management; Springer: Singapore, 2019; pp. 245–269. [Google Scholar]
- Pan, T.T.; Chyngyz, E.; Sun, D.W.; Paliwal, J.; Pu, H. Pathogenetic process monitoring and early detection of pear black spot disease caused by Alternaria alternata using hyperspectral imaging. Postharvest Biol. Technol. 2019, 154, 96–104. [Google Scholar] [CrossRef]
- RUSSELLPE A century of fungicide evolution. J. Agric. Sci. 2005, 143, 11–25. [CrossRef]
- Thind, T. Fungicides in Plant Disease Management. Approaches Trends Plant Dis. Manag. 2014, 13, 243–263. [Google Scholar]
- Zhu, Y.; Chen, Y.; Wang, S.Y.; Shi, X.C.; Herrera-Balandrano, D.D.; Polo, V.; Laborda, P. Peel Diffusion and Antifungal Efficacy of Different Fungicides in Pear Fruit: Structure-Diffusion-Activity Relationships. J. Fungi 2022, 8, 547. [Google Scholar] [CrossRef] [PubMed]
- Lamichhane, J.R.; Dachbrodt-Saaydeh, S.; Kudsk, P.; Messéan, A. Toward a Reduced Reliance on Conventional Pesticides in European Agriculture. Plant Dis. 2015, 100, 10–24. [Google Scholar] [CrossRef]
- Mnif, I.; Ghribi, D. Potential of bacterial derived biopesticides in pest management. Crop Prot. 2015, 77, 52–64. [Google Scholar] [CrossRef]
- Fira, D.; Dimkić, I.; Berić, T.; Lozo, J.; Stanković, S. Biological control of plant pathogens by Bacillus species. J. Biotechnol. 2018, 285, 44–55. [Google Scholar] [CrossRef] [PubMed]
- Zhao, X.; Kuipers, O.P. Identification and classification of known and putative antimicrobial compounds produced by a wide variety of Bacillales species. BMC Genom. 2016, 17, 882. [Google Scholar] [CrossRef]
- Melnick, R.L.; Zidack, N.K.; Bailey, B.A.; Maximova, S.N.; Guiltinan, M.; Backman, P.A. Bacterial endophytes: Bacillus spp. from annual crops as potential biological control agents of black pod rot of cacao. Biol. Control 2008, 46, 46–56. [Google Scholar] [CrossRef]
- Villa-Rodríguez, E.; Parra-Cota, F.; Castro-Longoria, E.; López-Cervantes, J.; de los Santos-Villalobos, S. Bacillus subtilis TE3: A promising biological control agent against Bipolaris sorokiniana, the causal agent of spot blotch in wheat (Triticum turgidum L. subsp. durum). Biol. Control 2019, 132, 135–143. [Google Scholar] [CrossRef]
- Samaras, A.; Hadjipetrou, C.; Karaoglanidis, G. Bacillus amyloliquefaciens strain QST713 may contribute to the management of SDHI resistance in Botrytis cinerea. Pest Manag. Sci. 2021, 77, 1316–1327. [Google Scholar] [CrossRef]
- Joshi, R.; McSpadden Gardener, B.B. Identification and characterization of novel genetic markers associated with biological control activities in Bacillus subtilis. Phytopathology 2006, 96, 145–154. [Google Scholar] [CrossRef]
- Asano, Y.; Onishi, H.; Tajima, K.; Shinozawa, T. Flagellin as a Biomarker for Bacillus substilis Strains: Application to the DB9011 Strain and the Study of Interspecific Diversity in Amino-acid Sequences. Biosci. Biotechnol. Biochem. 2001, 65, 1218–1222. [Google Scholar]
- Dimopoulou, A.; Theologidis, I.; Benaki, D.; Koukounia, M.; Zervakou, A.; Tzima, A.; Skandalis, N. Direct Antibiotic Activity of Bacillibactin Broadens the Biocontrol Range of Bacillus amyloliquefaciens MBI600. mSphere 2021, 6, 37621. [Google Scholar] [CrossRef] [PubMed]
- Luo, L.Y.; Jiang, Z.Y.; Sun, C.H.; Yin, W.; Chen, X.; Qi, Y.B.; Liu, X.J.; Zhong, Y.J. Isolation and Identification of Bacillus velezensis TMQ-KSL-1 and the Biocontrol Effect of Its Fermentation Broth on Tomato Root-Knot Nematodes. 2024. Available online: https://kns.cnki.net/kcms2/article/abstract?v=C4JADW50D8tKaK2-_yyiWpxVKw3oV2c5pFQT7dEgDp8GNwKmI0y0HHdmqdfAt2bvXUpTI5BdbbMBBgUFAkoe9lOgW-H2d_k8BVWBpCyN_6CyWw5SyVK-sirkPi83epUxpJ8m_OFOzKR5gufrwNCYbXNNNBIAncxiXBFVE4G-nKZZovcObHOvWw==&uniplatform=NZKPT&language=CHS (accessed on 13 April 2025).
- Hao, J.H.; Lin, S.N.; Wu, Z.F.; Wang, N.; Zhan, F.Q.; Yingwu, S.H.I.; Huifang, B.A.O. Effect of Paenibacillus polymyxa JE53 on Korla Pear Black Spot Pathogen and Fruit Quality during Storage. Chin. J. Biol. Control 2023, 39, 1266. [Google Scholar]
- Bi, Q.; Lu, F.; Wu, J. Combination of Bacillus tequilensis with difenoconazole to control pear black spot and the related synergistic mechanism. Front. Microbiol. 2024, 15, 1405039. [Google Scholar] [CrossRef]
- Carrassi, A.; Soligo, D.; Vogel, G.; Lambertenghi-Deliliers, G.; Zambon, J.J. Identification of Actinobacillus actinomycetemcomitans by gold immunolabeling and scanning electron microscopy. J. Periodontol. 1990, 61, 249–253. [Google Scholar] [CrossRef]
- O’Reilly, T.; Rosendal, S.; Niven, D.F. Porcine haemophili and actinobacilli: Characterization by means of API test strips and possible taxonomic implications. Can. J. Microbiol. 1984, 30, 1229–1238. [Google Scholar] [CrossRef]
- Prins, T.; Broothaerts, W.; Burns, M.; Demsar, T.; Edelmann, S.; Papazova, N.; Taverniers, I. Guidance on the Selection and Use of DNA Extraction Methods; Technical Report JRC134298-EUR 31809 EN; European Commission: Brussels, Belgium, 2024. [Google Scholar]
- Yoon, S.; Ha, S.; Kwon, S.; Lim, J.; Kim, Y.; Seo, H.; Chun, J. Introducing EzBioCloud: A taxonomically united database of 16S rRNA gene sequences and whole-genome assemblies. Int. J. Syst. Evol. Microbiol. 2017, 67, 1613–1617. [Google Scholar] [CrossRef]
- Ranneby, B. The maximum spacing method. An estimation method related to the maximum likelihood method. Scand. J. Stat. 1984, 11, 93–112. [Google Scholar]
- Grant, J.R.; Enns, E.; Marinier, E.; Mandal, A.; Herman, E.K.; Chen, C.Y.; Stothard, P. Proksee: In-depth characterization and visualization of bacterial genomes. Nucleic Acids Res. 2023, 51, W484–W492. [Google Scholar] [CrossRef]
- Liu, D.; Zhang, Y.; Fan, G.; Sun, D.; Zhang, X.; Yu, Z.; Ma, J. IPGA: A handy integrated prokaryotes genome and pan-genome analysis web service. Imeta 2022, 1, e55. [Google Scholar] [CrossRef]
- Blin, K.; Shaw, S.; Kloosterman, A.M.; Charlop-Powers, Z.; Van Wezel, G.P.; Medema, M.H.; Weber, T. AntiSMASH 6.0: Improving cluster detection and comparison capabilities. Nucleic Acids Res. 2021, 49, W29–W35. [Google Scholar] [CrossRef]
- Cantarel, B.L.; Coutinho, P.M.; Rancurel, C.; Bernard, T.; Lombard, V.; Henrissat, B. The Carbohydrate-Active EnZymes database (CAZy): An expert resource for glycogenomics. Nucleic Acids Res. 2009, 37 (Suppl. S1), D233–D238. [Google Scholar] [CrossRef] [PubMed]
- Kennedy, M.; Krouse, D. Strategies for improving fermentation medium performance: A review. J. Ind. Microbiol. Biotechnol. 1999, 23, 456–475. [Google Scholar] [CrossRef]
- Kim, P.I.; Bai, H.; Bai, D.; Chae, H.; Chung, S.; Kim, Y.; Chi, Y.T. Purification and characterization of a lipopeptide produced by Bacillus thuringiensis CMB26. J. Appl. Microbiol. 2004, 97, 942–949. [Google Scholar] [CrossRef]
- King, T.P. Separation of proteins by ammonium sulfate gradient solubilization. Biochemistry 1972, 11, 367–371. [Google Scholar] [CrossRef] [PubMed]
- Wu, J.; Alam, M.A.; Pan, Y.; Huang, D.; Wang, Z.; Wang, T. Enhanced extraction of lipids from microalgae with eco-friendly mixture of methanol and ethyl acetate for biodiesel production. J. Taiwan Inst. Chem. Eng. 2017, 71, 323–329. [Google Scholar] [CrossRef]
- Nazik, H.; Sass, G.; Déziel, E.; Stevens, D.A. Aspergillus is inhibited by Pseudomonas aeruginosa volatiles. J. Fungi. 2020, 6, 118. [Google Scholar] [CrossRef]
- Kaur, T.; Sharma, D.; Kaur, A.; Manhas, R.K. Antagonistic and plant growth promoting activities of endophytic and soil actinomycetes. Arch. Phytopathol. Plant Prot. 2013, 46, 1756–1768. [Google Scholar] [CrossRef]
- Bhutani, N.; Maheshwari, R.; Kumar, P.; Dahiya, R.; Suneja, P. Bioprospecting for extracellular enzymes from endophytic bacteria isolated from Vigna radiata and Cajanus cajan. J. Appl. Biol. Biotechnol. 2021, 9, 26–34. [Google Scholar]
- Ruiz-García, C.; Béjar, V.; Martínez-Checa, F.; Llamas, I.; Quesada, E. Bacillus velezensis sp. nov., a surfactant-producing bacterium isolated from the river Velez in Malaga; southern Spain. Int. J. Syst. Evol. Microbiol. 2005, 55, 191–195. [Google Scholar] [CrossRef]
- Bao, P.; Xiao, K.; Wang, H.; Xu, H.; Xu, P.P.; Jia, Y.; Häggblom, M.M.; Zhu, Y.G. Characterization and Potential Applications of a Selenium Nanoparticle Producing and Nitrate Reducing Bacterium Bacillus oryziterrae sp. nov. Sci. Rep. 2016, 6, 34054. [Google Scholar] [CrossRef] [PubMed]
- Sumpavapol, P.; Tongyonk, L.; Tanasupawat, S.; Chokesajjawatee, N.; Luxananil, P.; Visessanguan, W. Bacillus siamensis sp. nov., isolated from salted crab (poo-khem) in Thailand. Int. J. Syst. Evol. Microbiol. 2010, 60 Pt 10, 2364–2370. [Google Scholar] [CrossRef] [PubMed]
- Fazle Rabbee, M.; Baek, K. Antimicrobial activities of lipopeptides and polyketides of Bacillus velezensis for agricultural applications. Molecules 2020, 25, 4973. [Google Scholar] [CrossRef]
- Liang, X.; Ishfaq, S.; Liu, Y.; Jijakli, M.H.; Zhou, X.; Yang, X.; Guo, W. Identification and genomic insights into a strain of Bacillus velezensis with phytopathogen-inhibiting and plant growth-promoting properties. Microbiol. Res. 2024, 285, 127745. [Google Scholar] [CrossRef] [PubMed]
- Yang, X.; Zhang, F.; Wang, J.; Tian, C.; Meng, X. Characterization of Bacillus velezensis YTQ3 as a potential biocontrol agent against Botrytis cinerea. Postharvest Biol. Technol. 2025, 223, 113443. [Google Scholar] [CrossRef]
- Zhou, W.; Li, M.; Achal, V. A comprehensive review on environmental and human health impacts of chemical pesticide usage. Emerg. Contam. 2024, 11, 100410. [Google Scholar] [CrossRef]
- Franco-Duarte, R.; Černáková, L.; Kadam, S.; Kaushik, K.; Salehi, B.; Bevilacqua, A.; Rodrigues, C.F. Advances in chemical and biological methods to identify microorganisms—From past to present. Microorganisms 2019, 7, 130. [Google Scholar] [CrossRef]
- Priest, F.G. Systematics and ecology of Bacillus. In Bacillus subtilis and Other Gram-Positive Bacteria: Biochemistry, Physiology, and Molecular Genetics; Wiley: Hoboken, NJ, USA, 1993; pp. 1–16. [Google Scholar]
- Lahlali, R.; Ezrari, S.; Radouane, N.; Kenfaoui, J.; Esmaeel, Q.; El Hamss, H.; Barka, E.A. Biological control of plant pathogens: A global perspective. Microorganisms 2022, 10, 596. [Google Scholar] [CrossRef]
- Chen, W.; Juang, R.; Wei, Y. Applications of a lipopeptide biosurfactant, surfactin, produced by microorganisms. Biochem. Eng. J. 2015, 103, 158–169. [Google Scholar] [CrossRef]
- Medeot, D.B.; Bertorello, C.M.; Liaudat, J.P.; Alvarez, F.; Flores-Cáceres, M.L.; Jofré, E. Improvement of biomass and cyclic lipopeptides production in Bacillus amyloliquefaciens MEP218 by modifying carbon and nitrogen sources and ratios of the culture media. Biol. Control 2017, 115, 119–128. [Google Scholar] [CrossRef]
- Wei, X.; Yang, Q.; Solairaj, D.; Godana, E.A.; Zhang, X.; Li, Y.; Zhang, H. Biological Control of Black Spot Disease in Cherry Tomato Caused by Alternaria alternata with Bacillus velezensis T3. Foods 2025, 14, 1700. [Google Scholar] [CrossRef] [PubMed]
- Sam-On, M.F.S.; Mustafa, S.; Hashim, A.M.; Yusof, M.T.; Zulkifly, S.; Malek, A.Z.A.; Asrore, M.S.M. Mining the genome of Bacillus velezensis FS26 for probiotic markers and secondary metabolites with antimicrobial properties against aquaculture pathogens. Microb. Pathog. 2023, 181, 106161. [Google Scholar] [CrossRef] [PubMed]
- Kurth, C.; Kage, H.; Nett, M. Siderophores as molecular tools in medical and environmental applications. Org. Biomol. Chem. 2016, 14, 8212–8227. [Google Scholar] [CrossRef] [PubMed]
- Ahmad, T.; Xing, F.; Nie, C.; Cao, C.Y.; Xiao, Y.; Yu, X.; Moosa, A.; Liu, Y. Biocontrol potential of lipopeptides produced by the novel Bacillus subtilis strain Y17B against postharvest Alternaria fruit rot of cherry. Front. Microbiol. 2023, 14, 1150217. [Google Scholar] [CrossRef]
- Xu, W.; Wang, H.; Lv, Z.; Shi, Y.; Wang, Z. Antifungal activity and functional components of cell-free supernatant from Bacillus amyloliquefaciens LZN01 inhibit Fusarium oxysporum f. sp. niveum growth. Biotechnol. Biotechnol. Equip. 2019, 33, 1042–1052. [Google Scholar] [CrossRef]
- Yue, Y.; Wang, Z.; Zhong, T.; Guo, M.; Huang, L.; Yang, L.; Du, M. Antifungal mechanisms of volatile organic compounds produced by Pseudomonas fluorescens ZX as biological fumigants against Botrytis cinerea. Microbiol. Res. 2023, 267, 127253. [Google Scholar] [CrossRef]
- Li, X.; Wang, X.; Shi, X.; Wang, B.; Li, M.; Wang, Q.; Zhang, S. Antifungal effect of volatile organic compounds from Bacillus velezensis CT32 against Verticillium dahliae and Fusarium oxysporum. Processes 2020, 8, 1674. [Google Scholar] [CrossRef]

| Test Project | Result | |||
|---|---|---|---|---|
| TRMB57782 | B. velezensis CR-502T [43] | B. subtilis NCIB 3610T [44] | B. siamensis KCTC 13613T [45] | |
| Carbohydrate Acidogenesis | ||||
| D-glucose | + | + | + | + |
| D-Xylose | - | + | - | + |
| L-Arabinose | + | + | + | + |
| D-Ribose | + | + | Ne | + |
| Lactose | + | + | - | + |
| Maltose | - | + | + | + |
| Sucrose | - | + | + | + |
| Glycogen | + | + | - | + |
| Inositol | + | + | + | + |
| Mannitol | + | + | + | + |
| Sorbitol | + | + | + | Ne |
| Salicin | + | + | + | + |
| D-Melezitose | + | Ne | Ne | - |
| D-Galactose | - | Ne | Ne | - |
| D-Fructose | + | + | + | Ne |
| Nitrogen Source/Metabolism | ||||
| Nitrate Reduction | + | + | + | + |
| Citrate Utilization | - | - | + | - |
| Urease | - | - | - | - |
| Esculin Hydrolysis | + | + | Ne | + |
| Gelatin Hydrolysis | + | + | + | + |
| Enzyme Activity | ||||
| Oxidase | + | + | + | - |
| Catalase | + | + | + | + |
| Starch Hydrolysis | + | + | + | + |
| Casein Hydrolysis | + | + | + | + |
| Method | Treatment | 7 d | 14 d | 21 d | |||
|---|---|---|---|---|---|---|---|
| Disease Index | Control Efficacy % | Disease Index | Control Efficacy % | Disease Index | Control Efficacy % | ||
| Prevention | Sterile water | 20.00 ± 0.00 a | —— | 58.76 ± 6.11 a | —— | 98.67 ± 2.31 a | —— |
| Bacterial solution | 8.67 ± 1.16 b | 75.00 ± 3.27 | 10.67 ± 1.16 b | 86.00 ± 0.82 | 12.67 ± 2.31 c | 86.67 ± 0.47 | |
| Flusilazole | 6.00 ± 2.00 c | 74.00 ± 0.82 | 16.67 ± 1.16 b | 85.00 ± 0.00 | 19.33 ± 1.16 b | 86.33 ± 0.47 | |
| Treatment | Sterile water | 20.00 ± 0.00 a | —— | 55.33 ± 4.16 a | —— | 98.67 ± 2.31 a | —— |
| Bacterial solution | 8.00 ± 2.00 b | 80.67 ± 2.89 | 55.33 ± 4.16 a | 88.33 ± 1.53 | 14.00 ± 4.00 b | 86.33 ± 5.78 | |
| Flusilazole | 10.00 ± 2.00 b | 74.67 ± 1.53 | 17.33 ± 1.16 b | 85.67 ± 5.78 | 19.33 ± 1.16 b | 84.67 ± 2.52 | |
| Method | Treatment | 7 d | 14 d | ||
|---|---|---|---|---|---|
| Lesion Area | Control Efficacy % | Lesion Area | Control Efficacy % | ||
| Prevention | Sterile water | 13.11 ± 6.35 a | - | 37.03 ± 8.02 a | - |
| Bacterial solution | 1.13 ± 0.04 b | 91.38 | 13.82 ± 0.06 b | 96.27 | |
| Flusilazole | 1.13 ± 0.09 b | 98.52 | 13.00 ± 0.02 b | 96.49 | |
| Treatment | Sterile water | 125.83 ± 29.79 a | - | 270.50 ± 8.78 a | - |
| Bacterial solution | 26.56 ± 7.70 b | 78.89 | 49.50 ± 4.61 b | 81.70 | |
| Flusilazole | 21.89 ± 1.53 b | 82.60 | 42.83 ± 1.35 b | 84.17 | |
| Method | Treatment | 3 d | 7 d | 14 d | |||
|---|---|---|---|---|---|---|---|
| Disease Index Control Efficacy % | Disease Index | Control Efficacy % | Disease Index | Control Efficacy% | |||
| Prevention | Sterile water | 105.43 ± 3.94 a | - | 530.87 ± 131.78 a | - | 1225.86 ± 422.05 a | - |
| Bacterial solution | 60.05 ± 8.17 b | 40.19 | 183.94 ± 9.85 b | 65.35 | 335.18 ± 17.03 b | 72.65 | |
| Flusilazole | 4.14 ± 0.12 c | 96.07 | 39.64 ± 10.15 b | 92.53 | 200.51 ± 18.09 b | 83.64 | |
| Treatment | Sterile water | 85.67 ± 5.01 a | - | 527.20 ± 26.98 a | - | 1245.06 ± 68.56 a | - |
| Bacterial solution | 48.11 ± 4.09 b | 43.84 | 382.57 ± 38.21 b | 27.43 | 753.44 ± 24.30 b | 60.51 | |
| Flusilazole | 37.07 ± 2.77 c | 56.72 | 218.38 ± 31.84 c | 58.58 | 428.20 ± 44.10 c | 65.61 | |
Disclaimer/Publisher’s Note: The statements, opinions and data contained in all publications are solely those of the individual author(s) and contributor(s) and not of MDPI and/or the editor(s). MDPI and/or the editor(s) disclaim responsibility for any injury to people or property resulting from any ideas, methods, instructions or products referred to in the content. |
© 2025 by the authors. Licensee MDPI, Basel, Switzerland. This article is an open access article distributed under the terms and conditions of the Creative Commons Attribution (CC BY) license (https://creativecommons.org/licenses/by/4.0/).
Share and Cite
Liu, C.; Wang, T.; Zhang, Y.; Jiang, H.; Luo, X. Biocontrol Effect and Antibacterial Mechanism of Bacillus velezensis TRMB57782 Against Alternaria gaisen Blotch in Korla Pears. Biology 2025, 14, 793. https://doi.org/10.3390/biology14070793
Liu C, Wang T, Zhang Y, Jiang H, Luo X. Biocontrol Effect and Antibacterial Mechanism of Bacillus velezensis TRMB57782 Against Alternaria gaisen Blotch in Korla Pears. Biology. 2025; 14(7):793. https://doi.org/10.3390/biology14070793
Chicago/Turabian StyleLiu, Chaowen, Tiancai Wang, Yuxin Zhang, Hui Jiang, and Xiaoxia Luo. 2025. "Biocontrol Effect and Antibacterial Mechanism of Bacillus velezensis TRMB57782 Against Alternaria gaisen Blotch in Korla Pears" Biology 14, no. 7: 793. https://doi.org/10.3390/biology14070793
APA StyleLiu, C., Wang, T., Zhang, Y., Jiang, H., & Luo, X. (2025). Biocontrol Effect and Antibacterial Mechanism of Bacillus velezensis TRMB57782 Against Alternaria gaisen Blotch in Korla Pears. Biology, 14(7), 793. https://doi.org/10.3390/biology14070793
